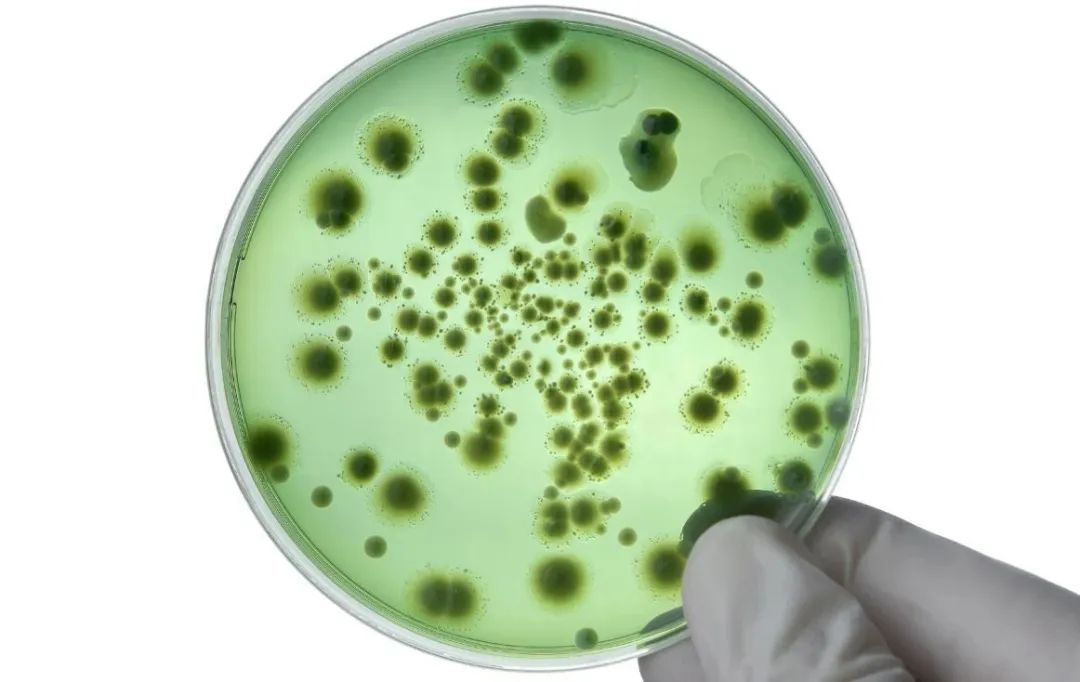

网购时代,拆快递成为解压般的存在。沉迷在快乐中,很多人没有留意到,一些“不速之客”也趁机溜进了家中。
前不久,美国加利福尼亚的尼娅姆·佐科在家里看到了最不想看到的东西。起初,她只是在厨房中发现了几只狂奔的小蟑螂,但很快,蟑螂数量迅速翻倍,地上、桌面、橱柜里到处都是。
尼娅姆一家很注重卫生,甚至会定期驱虫,这些蟑螂从何而来?在经过全面消杀后,灭虫公司的工作人员告诉她,蟑螂很可能来自快递包装纸盒中的虫卵。

尼娅姆将经历发在网上后引发大量讨论。有网友表示感同身受,说:“自从在拆快递时亲眼看到两只蟑螂爬出来,便没在室内拆过快递了。”|图源:网络
在国内,同样有不少人被快递包装上的“赠品”狠狠坑过。
来自郑州的李女士前不久网购了几袋薯片,打开箱子后,她透过袋子觉得薯片颜色不对劲。为了方便后续退货,她立刻撕开包装尝了一下,发现食物并没有变质。
然而到了晚上,李女士腹部开始剧烈疼痛,并出现腹泻和脱水的症状。去医院后,医生在她的粪便中检测出超标的大肠杆菌。进一步检测发现,薯片上的细菌含量符合标准,因此,李女士怀疑一切都是因为拆快递后没有洗手就试吃导致的。
图源:ShipSaving
01
最极端的时候,不干净的快递还会致命。
2013年,山东东营的刘先生为女儿网购了一双皮鞋,收到货后,发现鞋盒像被汽油浸泡过一样,还有刺激性气味。他立刻把鞋放到阳台散味,还顺手用纸擦掉了沾在鞋上的黑色不明物体。
很快,刘先生出现头晕、咳嗽、腹痛等症状,到医院后,健康迅速恶化,开始全身抽搐,血氧饱和度也急速下降。当天晚上,刘先生就因抢救无效死亡。
警方后期调查发现,和夺命快递一起运送的另一个快递里,含有违规化学品氟乙酸甲酯。运输过程中,氟乙酸甲酯发生泄漏并污染了刘先生的快递,这才导致悲剧发生。
最终,快递公司和寄件方都受到了法律制裁|图源:山东电视台
看到这里,大家先不必惊慌,毕竟快递包裹里有违禁品还发生泄漏,是极小概率事件。另外,医生也表示,健康的免疫系统可以隔绝大部分细菌。
不过,这些案例同样向我们传达出一个信息:快递包裹远比我们想象的脏。
图源:网络
到底有多脏呢?美国一个团队曾对三种快递包装进行检测:零售包装袋、小快递盒和大快递箱。
他们分别在不同包装上取样,然后在实验室中进行微生物培养并计算样品的菌落形成单位。菌落形成单位是计算细菌、真菌数量的一种方法,数值越高代表活菌数量越多。通过计算三种快递包装样品的菌落形成单位数量,研究人员可大致反推出每种快递包装上活菌的多寡。
由于有时几个微生物会粘连起来形成一个菌落,所以菌落形成单位只是一种粗略的计算方式|图源:Oculyze
结果发现,最“干净”的是零售包装袋,每个包装袋平均有2900个菌落形成单位。其次干净的是大快递箱,每个大快递箱平均有780万个菌落形成单位。最脏的是小快递盒,每个平均有1000万个菌落形成单位。
在三种快递的包装上,占比最多的是革兰氏阴性菌,因为这些菌对某些抗生素具有抵抗性,所以更加有害。文章开头让李女士腹泻脱水的大肠杆菌就是革兰氏阴性菌的一种。
02
国内的情况也比较相似。曾经有医生随机选取了一个快递盒,就在其表面发现了大肠杆菌、金黄色葡萄球菌、腺病毒、合胞病毒等多种病原体。
快递包装上细菌、真菌这么多其实并不算特别出乎意料,想想分拣快递时,大多数包裹都是直接堆在马路上。运输和送达的过程中,快递也可能会沾染环境里的污染物,进一步增加其肮脏程度。
图源:Wikipedia by Simbiosc
快递包裹的纸箱对蟑螂等昆虫也具有致命的吸引力。首先,一些生物可以把纸箱当食物,胶水同样会释放出特殊味道引诱虫子。其次,硬纸板中间一般有较大缝隙,能够充当蟑螂的庇护所。纸箱还会吸收空气里的水分,如果恰巧储存在阴暗的房子里,无异于蟑螂的乐园。
03
那么,我们应该如何安全、卫生地拆快递呢?
医生建议在取快递时,可以用消毒液喷洒快递表面,如果没有消毒液,则尽量避免双手抱取包裹,以免把细菌等污染物蹭到衣物上。
图源:Pitney Bowes
拆快递时,应该先在桌子上垫一层旧报纸或其他纸张,最好用剪刀或者裁纸刀剪开胶带,切勿一着急直接用嘴咬,这样可能会让病原体直接进入身体。
处理完快递后,应该及时在流动水下用肥皂或者洗手液洗手。拆过的纸箱最好放在室外或者进行回收。
图源:Health Hub
为了自己和家人的健康,更为了防止“小强”们进入家中,谨慎地对待每一个快递包裹吧!
参考资料:
[1]https://www.newsweek.com/womans-life-escalates-nightmare-opening-innocent-package-1955717
[2]https://www.dailymail.co.uk/femail/article-13883275/homeowner-package-amazon-tiktok-cockroach-exterminator.html
[3]https://www.dailydot.com/news/costco-cardboard-box-warning/
[4]https://mp.weixin.qq.com/s/iEm8vnkUifx5gmuFaupzQA
[5]https://getcircuit.com/package-tracker/blog/germ-swabbing-package